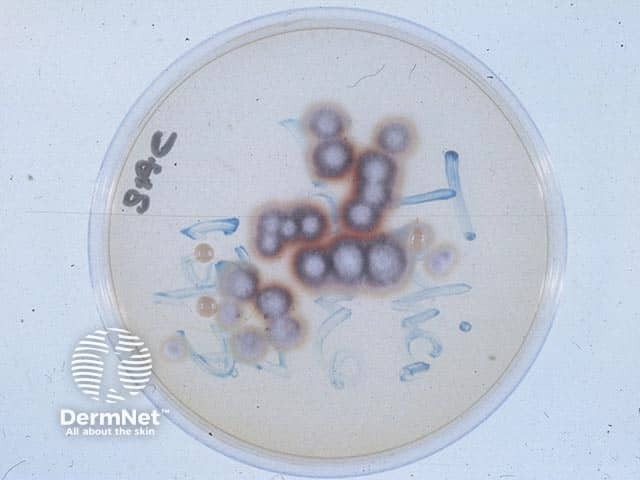
The dermatophyte T.rubrum growing on Sabouraud fungal culture medium

Main menu
Common skin conditions
NEWS
Join DermNet PRO
Read more
Quick links
Author: Dr Adeline Hillan, Royal Perth Hospital, Australia (2022)
Previous contributors: A/Prof Amanda Oakley, Dermatologist (2003)
Reviewing dermatologist: Dr Ian Coulson
Edited by the DermNet content department
Introduction Demographics Causes Clinical features Complications Diagnosis Differential diagnoses Treatment Prevention Outcome
Fungal infection of the nail, also known as onychomycosis, compromises over 50% of all nail disease with an estimated prevalence of 5.5%. They can affect the toenails, fingernails, or both.
Fungal nail infections are also known as tinea unguium in the case of dermatophyte infections.

Total fingernail onychomycosis in type 6 skin (ONYC-patient6)

Onychomycosis

White discolouration of the distal nail plate in superficial white onychomycosis (ONYC-patient1)

Proximal onychomycosis

Tinea unguium, toenails

Total onychomycosis due to Fusarium species (ONYC-patient7)
Onychomycosis is common in older aged adults (over 65 years), diabetics, immunocompromised patients (especially those with HIV disease), and athletes. Onychomycosis may be present amongst family members due to autosomal inheritance (HLA-DR8) or environmental factors. It rarely occurs in children.
Other associated comorbidities include: tinea pedis, tinea manuum, psoriasis, peripheral vascular disease, venous insufficiency, hallux valgus, smoking, asymmetric gait nail unit syndrome, Down syndrome, and obesity.
Predisposing patient factors include: chronic paronychia, hyperhidrosis (eg, with occlusive footwear), nail trauma, and using communal bathing or changing facilities.
Onychomycosis can be due to infection with dermatophytes or non-dermatophytes such as moulds and yeasts.
Emerging evidence of the role of biofilm in fungal nail disease may account for antifungal drug resistance and increased virulence.
Onychomycosis may affect a single nail or multiple, commonly affecting the first toenail. It may also affect the surrounding skin, however, very rarely causes systemic involvement.
Clinical types include:
Features that are observed include:
Onychomycosis may complicate other nail pathology such as trauma or psoriasis.
Candida infection of the nail plate generally results from paronychia and starts near the nail fold (the cuticle). The nail fold is swollen and red, lifted off the nail plate. White, yellow, green, or black marks appear on the nearby nail and spread. The nail may lift off its bed and is tender if you press on it.
Mould infections are similar in appearance to tinea unguium.
Fungal nail infections are often regarded as a trivial cosmetic problem. However, the effect it may have on one’s quality of life is undervalued as it can cause significant pain affecting full mobility and activities, and social stigma.
Physical examination of all nails, and a combination of tools, such as those listed below, may be used to improve speed and accuracy of diagnosis.
Dermoscopy may be able to differentiate between onychomycosis, traumatic onycholysis, and melanonychia. Common dermatoscopic findings include linear bands which round proximally and taper distally, discolouration, non-longitudinal homogenous or reverse triangular patterns, subungual keratosis, white/yellow streaks, and nail plate scales.
The pattern of fungal invasion is further divided into:
Clippings should be taken from the crumbling free edge of the affected nail.
Microscopic examination reviewed under light microscopy using potassium hydroxide (to dissolve keratinocyte material) is a quick test to assess for the presence of fungal hyphae, although it lacks sensitivity and specificity.
Histopathological assessment of nail clippings using haematoxylin-eosin, periodic acid-Schiff, or Grocott methenamine silver staining to visualise fungal hyphae is easy and sensitive. For more information, see histology stains and laboratory tests for fungal infection.

Onychomycosis pathology
Fungal cultures can identify the causative organism and is the standard diagnostic test, however, results can take weeks and a large specimen collection may be required. This technique requires the nail to be cleaned with 70% isopropyl alcohol and soapy water prior to specimen collection.
Samples should be taken prior to starting any treatment.

Trichophyton rubrum culture on agar slope
The dermatophyte T.rubrum growing on Sabouraud fungal culture medium
PCR testing quickly identifies the offending organism and is highly sensitive and specific. It is becoming more commonly available, however is more costly than microscopy or fungal culture testing.
Other techniques such as confocal microscopy, optical coherence tomography, infrared thermography, flow cytometry, immunochromatography, and mass spectrometry are currently being explored and rarely used.
A nail biopsy may also reveal characteristic histopathological features of onychomycosis.
Many other nail diseases may mimic the clinical signs of onychomycosis, hence the importance of diagnostic confirmation to ensure malignant conditions are not missed.
Treatment aims to eliminate the offending organism and restore the nail to health and a normal appearance. Fingernail infections are usually cured more quickly and effectively than toenail infections.
Mild infections affecting less than 50% of one or two nails may respond to topical antifungal medication, but cure usually requires an oral antifungal medication for several months.
These are often favoured before systemic treatments, if drug interactions are a concern.
With total nail involvement, medical nail avulsion using urea paste may enhance systemic antifungal efficacy.
These are widely used due to accessibility, low cost (some of them), and high efficacy; however, they may require an extended course especially for toenail involvement (3-4 months).
Infrared radiation emission by laser can eradicate nail fungi in 1–3 sessions, however the effectiveness of laser compared to systemic therapy is lacking. Photodynamic therapy, plasma therapy, iontophoresis or ultrasound are adjuncts to topical antifungal therapy thought to enhance the absorption of drug to nail.
Treatment should be individualised, and the patient should be counselled for the estimated time to cure.
Strategies to prevent recurrence include:
Approximately 20–25% of treated onychomycosis unfortunately relapse due to patient or pathogen factors such as poor circulation, advancing age, diabetes, immunosuppression, severe fungal nail clinical findings, mixed infections, and incomplete treatment. The Onychomycosis Severity Index can be used to predict response to therapy.